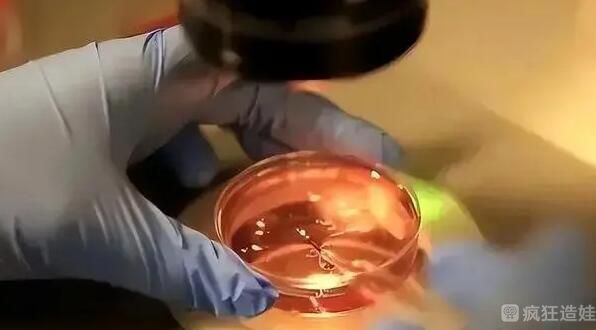

江门中心医院做供精供卵第三代试管婴儿吗?附其他试管婴儿医院推荐?
- 试管婴儿
- 2024-06-15 10:25
江门中心医院做供精供卵第三代试管婴儿吗?附其他试管婴儿医院推荐?三年前,老婆怀孕了,当时就不想要了。当她想要的时候,她从来没有想要过。然后她去江门市中心医院检查,说没有精子。睾丸穿刺完成。没有发现精子。不知道有没有治愈的可能。可以确定不是先天性无精子症。医生说,如果她想拥有自己的后代,可以使用睾丸显微精子提取技术。大概有40%的患者可以获得精子生下自己的后代,但是我手术后还是没有怀孕,所以想考虑做捐精试管婴儿。我也有个亲戚的卵子质量不太好,我就帮她问问这个医院能不能做卵子试管婴儿。请告诉我!
江门市中心医院的不能做捐精试管婴儿和捐卵试管婴儿。目前这家医院只能开展,第一代试管婴儿,第一代试管婴儿。目前这家医院没有精子库,卵子来源紧缺。如有需要,患者可前往广州大学第三附属医院、广东省妇幼保健院、广东省计划生育专科医院进行相应治疗。
目前江门能开展试管婴儿技术的医院只有两家,分别是江门市中心医院和江门市妇幼保健院。但这两家医院目前都无法开展精子和卵子试管婴儿。必要的话可以去广东省内其他城市的医院治疗。可以推荐一些好点的医院。让我们看一看。
医院地址:广东省江门市蓬江区海傍街23号
可用项目:丈夫精子人工授精,第一代和第。
是否进行精子和卵子捐献试管婴儿:否。
医院地址:广东省广州市荔湾区多宝路63号
可开展的项目:丈夫授精、人工授精技术授精、第一代、第二代、第三代试管婴儿。
是否进行精子和卵子捐献试管婴儿:是。
医院地址:广东省广州市番禺区南星大道521号和523号
可开展的项目:丈夫授精、人工授精技术授精、第一代、第二代、第三代试管婴儿。
是否进行精子和卵子捐献试管婴儿:是。
医院地址:广东省广州市越秀区梅冬路17号
可开展的项目:受精、供精人工授精技术、第一代和第二代试管婴儿。
是否进行精子和卵子捐献试管婴儿:是。
广东还有很多医院可以提供精子和卵子做供卵第三代试管婴儿,但是江门没有分布。不过现在交通发达,患者去其他城市治疗很方便,不用太担心。
江门市中心医院生殖中心自2001年开业以来,一直致力于男女不孕症及疑难杂症的诊治。已经帮助了很多家庭成功辅助怀孕,在当地有很好的口碑。如果患者需要试管婴儿,可以去这家医院做人工授精,第一代和第二代试管婴儿。需要做捐卵捐精的患者可以咨询生殖中心。当然,捐精的好医院还是很多的。以上可以做捐精试管婴儿的医院分享给大家,供大家参考。以上就是关于江门中心医院做供精供卵第三代试管婴儿吗?附其他试管婴儿医院推荐?的全部内容。如果还有疑惑的话欢迎咨询试管婴儿资讯分享平台的专业生殖顾问。

发表评论